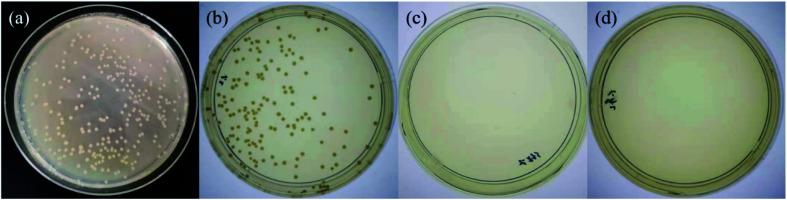
https://cdn.ncbi.nlm.nih.gov/pmc/blobs/e2fd/9048105/64ee632bcf37/c9ra09229c-f7.jpg
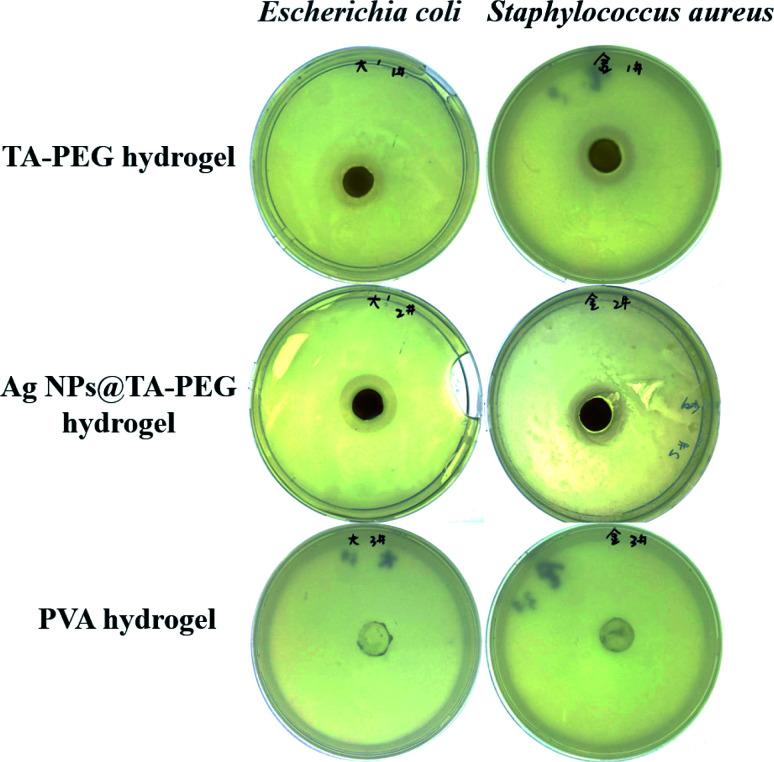
https://cdn.ncbi.nlm.nih.gov/pmc/blobs/e2fd/9048105/46ef7b589432/c9ra09229c-f6.jpg

单宁酸-聚乙二醇水凝胶的合成与表征:光延反应聚合
Synthesis and characterization of tannic acid-PEG hydrogel Mitsunobu polymerization.
作者信息
Chen Chen, Geng Xi-Wen, Pan Ya-Hui, Ma Yu-Ning, Ma Yu-Xia, Gao Shu-Zhong, Huang Xiao-Jun
机构信息
Key Laboratory of New Material Research Institute, Department of Acupuncture-Moxibustion and Tuina, Shandong University of Traditional Chinese Medicine Jinan 250355 China
Key Laboratory of Stem Cell and Translational TCM, Experimental Center, Shandong University of Traditional Chinese Medicine Jinan 250355 China.
出版信息
RSC Adv. 2020 Jan 9;10(3):1724-1732. doi: 10.1039/c9ra09229c. eCollection 2020 Jan 7.
Tannic acid (TA) based materials have received significant interest owing to their broad spectrum of chemical and biological properties. Herein, a novel tannic acid based hydrogel, TA-PEG hydrogel, was synthesized Mitsunobu polymerization/polycondensation, in which TA and polyethylene glycol (PEG) were simply crosslinked together by ether linkages. This method was performed in one pot, straightforward, metal free and robust, ignoring the strong ionic/hydrophobic interactions between tannic acid and PEG. Bearing catechol and pyrogallol units from TA, TA-PEG hydrogel did not only reduce the silver and gold precursor, but also served as a capping agent and stabilizer for the formed Au and Ag nanoparticles (NPs). Furthermore, the antioxidant activity of the hydrogel was excellent (94%) in the case of 1,1-diphenyl-2-picrylhydrazyl (DPPH) radical scavenging. TA-PEG hydrogel also showed antibacterial activity against and . This work suggested a new method leading to polyphenol based soft materials rather than a complex coacervated microstructure. The resulting TA-PEG hydrogel has potential application in biomedical materials.
基于单宁酸(TA)的材料因其广泛的化学和生物学特性而备受关注。在此,通过 Mitsunobu 聚合/缩聚反应合成了一种新型的基于单宁酸的水凝胶,即 TA-PEG 水凝胶,其中 TA 和聚乙二醇(PEG)通过醚键简单地交联在一起。该方法在一个反应釜中进行,操作简单、无金属且稳健,忽略了单宁酸和 PEG 之间强烈的离子/疏水相互作用。由于 TA 含有儿茶酚和邻苯三酚单元,TA-PEG 水凝胶不仅能还原银和金前驱体,还能作为所形成的金和银纳米颗粒(NPs)的封端剂和稳定剂。此外,在 1,1-二苯基-2-苦基肼(DPPH)自由基清除实验中,该水凝胶的抗氧化活性极佳(94%)。TA-PEG 水凝胶对[具体细菌名称 1]和[具体细菌名称 2]也表现出抗菌活性。这项工作提出了一种制备基于多酚的软材料的新方法,而非形成复杂的凝聚微结构。所得的 TA-PEG 水凝胶在生物医学材料方面具有潜在应用价值。